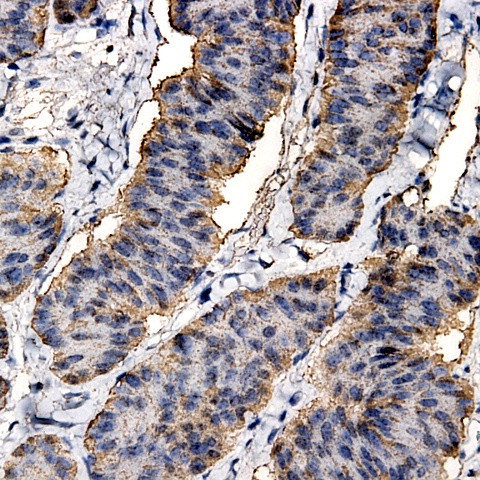
MMP-8 Antibody in Immunohistochemistry (Paraffin) (IHC (P))

Search
AbboMax
MMP-8 Polyclonal Antibody
{{$productOrderCtrl.translations['antibody.pdp.commerceCard.promotion.promotions']}}
{{$productOrderCtrl.translations['antibody.pdp.commerceCard.promotion.viewpromo']}}
{{$productOrderCtrl.translations['antibody.pdp.commerceCard.promotion.promocode']}}: {{promo.promoCode}} {{promo.promoTitle}} {{promo.promoDescription}}. {{$productOrderCtrl.translations['antibody.pdp.commerceCard.promotion.learnmore']}}
图: 1 / 2
MMP-8 Antibody (500-9884) in IHC (P)


产品信息
500-9884
种属反应
宿主/亚型
分类
类型
抗原
偶联物
形式
浓度
规格
纯化类型
保存液
内含物
保存条件
运输条件
产品详细信息
Positive control: Myosacorma
Cellular location: Cytoplasmic.
靶标信息
The MMP8 gene encodes matrix metalloproteinase-8, also known as collagenase-2, an enzyme belonging to the matrix metalloproteinase (MMP) family, which plays a pivotal role in the breakdown of extracellular matrix (ECM) components. MMP8 is primarily involved in the degradation of type I and III collagen, facilitating tissue remodeling and repair processes. This enzyme is produced by neutrophils and is active in areas of tissue inflammation and injury, where it modulates the ECM to aid in wound healing. MMP8 is implicated in various physiological processes, including embryonic development, angiogenesis, and bone remodeling. However, excessive or unregulated activity of MMP8 can lead to pathological conditions such as arthritis, periodontal disease, and cancer metastasis, where ECM degradation contributes to disease progression. Research into MMP8 aims to understand its regulation and involvement in disease states, providing insights into potential therapeutic strategies for targeting MMP activity in inflammatory and degenerative conditions.
仅用于科研。不用于诊断过程。未经明确授权不得转售。
篇参考文献 (0)
生物信息学
蛋白别名: Collagenase; collagenase 2; matrix metallo protease; matrix metalloproteinase 8 (neutrophil collagenase); Matrix metalloproteinase-8; Matrix metalloproteinase8; MMP; MMP 8; MMP-8; MMPs; Neutrophil collagenase; PMN leukocyte collagenase; PMNL CL; PMNL collagenase; PMNL-CL; PMNLCL; unnamed protein product
基因别名: CLG1; HNC; MMP-8; MMP8; PMNL-CL
UniProt ID: (Human) P22894
Entrez Gene ID: (Human) 4317